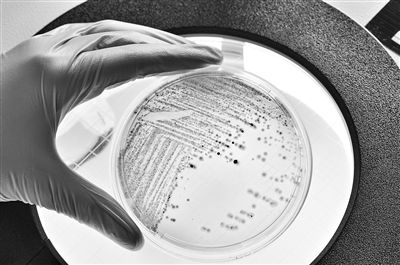
图为在培养皿中生长的大肠杆菌。 视觉中国供图

杏宇娱乐:细菌能储存“记忆”并传给“曾孙”?
图为在培养皿中生长的大肠杆菌。 视觉中国供图
记忆通常与高等生物有关。不过,美国得克萨斯大学奥斯汀分校的科学家日前开展的一项研究发现:尽管缺乏神经元、突触和神经系统,但当数百万只细菌聚集于同一表面时,它们能够形成类似于记忆的东西,比如何时一起游动、何时形成生物膜等,而且细菌至少可以将这些“记忆”传给自己的“曾孙”。进一步分析显示,看似平淡无奇的铁是细菌形成此种“记忆”的幕后功臣。相关论文刊载于《美国国家科学院院刊》。
那么,细菌真能形成“记忆”并传给后代吗?中国科学院微生物研究所微生物资源前期开发国家重点实验室研究员付钰告诉科技日报记者:“严格来说,得克萨斯大学奥斯汀分校科学家开展的这项研究所阐述的细菌‘记忆’并非生物学意义上的记忆,而是细菌基于铁元素浓度变化而产生的对外界刺激的反应。这使细菌在复杂环境下更好地生存与繁殖。”
“最新研究对我们应对细菌耐药性有启发意义,比如我们可以人为调节铁的浓度,从而减少细菌对感染部位的附着,降低细菌对抗生素的耐受,方便免疫系统清除病原细菌并加强抗生素的疗效。”付钰进一步强调。
铁是幕后功臣之一
包括人类在内的高等动物拥有记忆能力,这种能力能让高等动物不断适应环境的改变,快速作出正确的反应。研究显示,这种记忆能力源于神经组织。神经组织在接受外界刺激后会形成神经冲动,神经冲动对于特定刺激形成条件反射,并能在今后遇到同样刺激时作出相应的反应。
付钰介绍:“细菌虽然没有大脑,不能像高等动物那样记忆信息,但在某种意义上,它们确实具有‘记忆’机制。这种机制主要体现在它们对环境变化的适应性,以及对遗传信息和化学物质的传递上。”
细菌可以从环境中收集信息。如果它们经常遇到这种环境,它们能存储信息,并在以后快速访问这些信息,这对它们有利。
得克萨斯大学奥斯汀分校的科学家苏维克·巴塔查里亚领导的团队开展的这项最新研究发现,细菌不仅可以形成“记忆”,还可将“记忆”传给自己的后代。
科学家此前观察到,有过群聚运动(众多细菌在鞭毛驱动下进行的快速运动)经验的细菌会更愿意且更有能力成群结队地运动。巴塔查里亚等人希望厘清这一现象的内在原因。为此,他们设计了一种实验装置,可监测由超过1万个大肠杆菌细胞组成的群聚运动。一系列分析结果显示,这些大肠杆菌可以将形成群聚运动的“记忆”保留至少四代,也就是传给自己的“曾孙”,直到第七代才会完全消失。
那么,这种“记忆”是通过什么方式保留和传递的呢?答案指向了铁。铁是地球上最丰富的元素之一。在氧气出现于早期地球的大气中之前,铁在早期生命的许多细胞过程中发挥了关键作用,对生命的进化至关重要。
巴塔查里亚解释道,大肠杆菌的上述“记忆”机制源于大肠杆菌细胞内铁元素含量的变化。他们的观测结果显示,不同细菌含有不同水平的铁,这对于其细胞代谢非常重要。铁元素含量较低的大肠杆菌更容易成群结队运动。而那些细胞内铁含量较高的细菌则往往倾向原地不动,形成生物膜。这些大肠杆菌的后代,会继承其“父辈”细胞内的物质,从而继承了群聚运动的“记忆”。
研究人员推测,当铁含量较低时,细菌会快速集结,形成快速运动的群体,在环境中寻找铁。当铁含量高时,细菌可以原地附着并形成生物膜。
他们的最新研究还发现,人为升高或降低大肠杆菌细胞内铁元素的含量,可以缩短或延长“记忆”保存的时间。
付钰认为,铁作为生命活动中重要的元素,在细菌各种生化反应中发挥着重要作用。因此,铁浓度的变化可以调控细菌应对外界环境的方式,其实并不令人意外。
助力应对抗生素耐药性
巴塔查里亚表示,细菌知道何时形成群聚运动、何时形成生物膜的“记忆”。这一特点或许也在其感染人类时起到了重要的作用。因此,这些发现对于细菌感染的治疗和预防具有重要意义,有助于应对抗生素耐药性。巴塔查里亚强调,铁浓度绝对是治疗细菌感染的靶标之一,因为铁是决定细菌毒性的重要因素。
付钰解释说:“当铁元素浓度较高时,大肠杆菌倾向于停止运动形成生物膜,生物膜的形成可以提高细菌的耐药性。而当大肠杆菌体内的铁浓度较低时,细菌对抗生素的耐受性较差。这些都对我们应对细菌耐药有启发意义,比如我们可以通过改变铁的浓度使细菌难以形成生物膜,并降低其对抗生素的耐受性,从而高效地治疗感染。”
“微生物所表现出的‘记忆’可能基于各种机制,但归根结底,所有这些都是微生物在长期进化中形成的对外界环境变化的快速反应。小细菌拥有大智慧,无数有意思的现象等待科学家们一一解析。”付钰总结道。
相关新闻:
- 杏宇:周边游、“新中式”民俗游成主力军 2024-06-08
- 杏宇娱乐:海上“油”路 青春“挺进”超深2024-06-08
- 杏宇注册:证监会就《中国证监会行政处罚裁2024-06-08
- 杏宇官方:《财米油盐》| “三百六十行”2024-06-07
